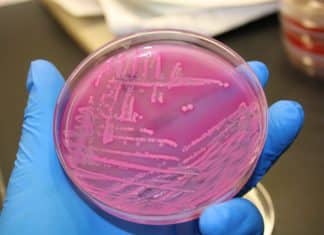

Attention Tofu Lovers! Now you can Get Drunk on your Favourite...
Tofu Lovers! Now you can Get Drunk on your Favourite Meat substitute
I don’t think there is a food in existence that can make people...
A Patch that’s got a Beat- Researchers Engineer Heart Patch Capable...
Engineer Heart Patch Capable of Undoing Damage to Cardiac Muscles
While a victim of heart attack may recover from the event, their heart often ends up...
Mitra Biotech Partners with Israeli Gotect Diagnostic
Mitra Biotech Partners with Israeli Gotect Diagnostic
Mitra Biotech, founded in 2010, headquartered in Greater Boston and maintaining a significant research and laboratory presence in...
Life Hacks by a Worm: Earthworms Found Thriving, Proliferating In Martian...
Earthworms Found Thriving, Proliferating In Martian Soil
“It may be doubted whether there are many other animals which have played so important a part in...
CSIR NET Dec – 2017 Results Are Out | Check Now
RESULT OF THE JOINT CSIR-UGC TEST FOR JUNIOR RESEARCH FELLOWSHIP (JRF) Held in Dec 2017 & June 2018
Check CSIR NET Dec 2017 Results
Check CSIR...
Research – Molecular Microbiologist @ University of Cambridge
Research - Molecular Microbiologist @ University of Cambridge
This job expires in :
The position is part of large collaborative grant (involving the Departments of Medicine...
Dissertation Research Training Program – Life Sciences @ CSIR-CCMB
Dissertation Research Training Program - Life Sciences @ CSIR-CCMB
Dissertation Research Training Program
CSIR-CCMB accepts applications from candidates pursuing M.Sc / M.Pharm/ M.Tech/ B.Pharm/ B.Tech in...
Google on a Spree, Partners with Key Players in Healthcare to...
Partners with Key Players to Advance Medical Imaging-google
Medical imaging is a critical pillar of modern healthcare: It's estimated that more than 300 million advanced imaging procedures...
Scientists Find Genetic Correlation between Intelligence and Life Span
Scientists Find Genetic Correlation between Intelligence and Life Span
"For the first time, we were able to use genetic information to point us towards specific...
PhD Programme Admissions 2017-18 @ Kuvempu University
PhD Programme Admissions 2017-18 @ Kuvempu University
This call expires in :
Applications are invited in the prescribed proforma from the eligible candidates for
enrolment to Ph.D....
Biotecnika Times – Newsletter 30.11.2017
APPCB Research Fellowship Scheme 2017
The Andhra Pradesh Pollution Control Board (APPCB), driven by the vision to foster
economic growth with efficient environmental.............. Read More
PhD Programme Admissions...
Bone-Derived Hormone Plays Key Role in Memory Maintenance, Study Says
Bone-Derived Hormone Plays Key Role in Memory Maintenance-study
Columbia University Medical Center (CUMC) has now announced results of its revolutionary study regarding a hormone (osteocalcin) made by...
Resilient Corals Provide a Glimmer of Hope to the Great Barrier...
Resilient Corals Provide a Glimmer of Hope to the Great Barrier Reef
The back-to-back bleaching events in 2016 and 2017 that killed many corals on the Great...
A Forthcoming Pandemic: Parkinson’s Disease
A Forthcoming Pandemic: fastest growing Parkinson’s Disease
“Pandemics are usually equated with infectious diseases like Zika, influenza, and HIV,” says Ray Dorsey, a neurologist at...
A Kill Switch for Microbes Gone Rogue
A Kill Switch for Microbes Gone Rogue- Latest Research
Over the past 60 years, human beings haven’t exactly been good stewards of their own environment...
10% of Drugs in Developing Countries are Substandard or Fake, WHO...
10% of Drugs in Developing Countries are Substandard or Fake-WHO
An estimated one in 10 medicines in poor countries are counterfeit and likely responsible for the deaths...
Rotavirus Vaccine to be Introduced in Additional States
Rotavirus Vaccine to be Introduced in Additional States
The Rotavac vaccine developed under the joint collaboration between India and the United States in the area...
Hippocampus haema, a New Species of Seahorse
Hippocampus haema, a New Species of Seahorse
Seahorses are intriguing little creatures. They bob and drift in water, awkwardly swimming while constantly eating. They look...
New Study Provides Insights into Regeneration of Blood Vessels
New Study Provides Insights into Regeneration of Blood Vessels
"Our research shows that the formation of fully functional blood vessels requires activation of protein kinase...
PhD Programme Admissions @ Cologne Graduate School of Ageing Research
PhD Programme Admissions @ Cologne Graduate School of Ageing Research
This call expires in :
We offer an international research environment, characterized by outstanding ageing research,...